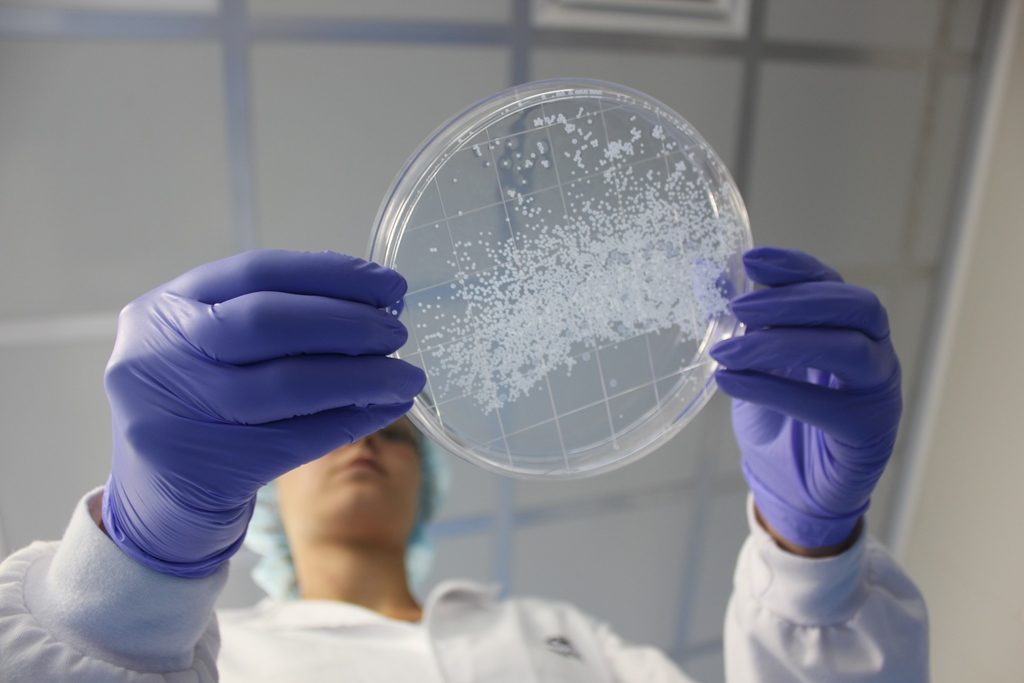

أعلنت شركة “بنتا” للأدوية في بيان، أن “باحثين لبنانيين توصلوا إلى نتائج واعدة لدراسات وتجارب أجروها على حيوانات بهدف القضاء على مرض السكري، ويستعدون لإطلاق مرحلة التجارب السريرية على البشر الذين يعانون مرض السكري من النمط الأول، او ما يعرف بالسكري الذي يعتمد على الإنسولين الخارجي”.
وأشار البيان الى أن “الأبحاث التي تجريها شركة بنتا اللبنانية للصناعات الدوائية (BPI) تركز على تقليص كمية الإنسولين الخارجية المطلوبة، وعلى تجنب حاجة المريض إلى الأدوية المثبطة للمناعة. وقد استعانت الشركة عوضا عن ذلك بتكنولوجيا تغليف المواد الحيوية بواسطة تقنية عالية ومحددة للغاية، مما سمح بتغليف الخلايا الحية تحت الجلد من دون الحاجة إلى العلاج المثبط للمناعة”.
وأوضح البيان أن الشركة هي “أول مصنع لبناني للأدوية يجري تجارب سريرية للعلاجات المبتكرة، وهذه التجارب التي يتولى إجراءها قسم التكنولوجيا الحيوية في الشركة، وهي الأولى من نوعها في لبنان والمنطقة العربية، تتم بالتعاون مع مجموعة باحثين في مجالات الغدد الصماء والسكري والتكنولوجيا الحيوية والفيزياء التطبيقية، ومع شركة Encapsulife في الولايات المتحدة”.
وكشف البيان أن “الباحثين حصلوا على بيانات واعدة من الدراسات والتجارب التي أجروها على الحيوانات، كالقوارض والكلبيات وفصائل القردة، وتم تقديم البروتوكول السريري إلى مجلس المراجعة الداخلية (Institutional Review Board) لبدء التجارب السريرية”، لافتا الى أنه “تشرف على التبرع بالبنكرياس البشري لهذه التجارب الهيئة الوطنية لوهب وزرع الاعضاء والانسجة البشرية (NOD-LB)، بالتعاون مع وزارة الصحة العامة”.
تنوري
وأمل رئيس مجلس إدارة “بنتا” برنار تنوري أن “يتمكن لبنان، من خلال هذه الأبحاث، من المساهمة في تحقيق تقدم صحي كبير للبشرية جمعاء”. وقال: “نفتخر بفريقنا البحثي وبكفايات اللبنانيين العلمية، ونؤمن بأن لدينا في لبنان القدرات والمؤهلات التي تتيح لنا تحقيق الإنجازات الطبية على صعيد محلي وعالمي متى توافرت لها الإمكانات التكنولوجية والدعم اللازم”.
أضاف: “الشركة تدعم حاليا عددا من مشاريع الأبحاث والتطوير الصحية الإبتكارية، وهي مصممة على المضي إلى النهاية في هذا المشروع العلمي، ومستعدة لتأمين كل الإمكانات اللازمة له، سعيا إلى المساعدة في تغيير حياة الملايين من الناس حول العالم”.
وطنية
شريط الأخبار
- وزارة الأشغال: تأهيل طريق ضهر البيدر حتى شتورة بكلفة 8.5 ملايين دولار
- الحصيلة الإجمالية للعدوان : 3468 شهيداً و 10577 جريحا
- فراس حمدان لوزيرة التربية: أعيدوا النظر في الامتحانات بعد مجزرة طريق الخردلي
- حقنة واعدة للسرطان تقضي على الأورام بالكامل
- “ظروف صحية صعبة”… هل يُخلى سبيل فضل شاكر بعد قرار اللجنة الطبية؟!
- انتهت المطاردة.. الأمن الكويتي يلقي القبض على السجناء الهاربين الثلاثة
- كلية الطب في جامعة بيروت العربية تحصد المركز الثاني في اليوم البحثي الوطني الثالث 2026
- مفاجأة داخل ليفربول.. رسالة صلاح كانت سبباً في إقالة سلوت